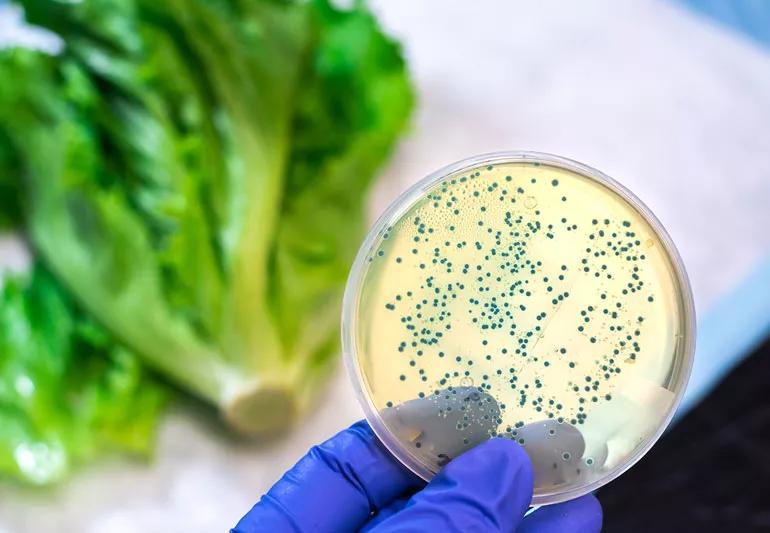

The short answer from a wellness dietitian
Image content: This image is available to view online.
View image online (https://assets.clevelandclinic.org/transform/f0b348ee-5334-47fa-8e2c-8925982ddc29/foodRecall-1190512194-770x533-1_jpg)
bacteria on lettuce
A: The U.S. Food and Drug Administration (FDA) recalls foods that have been contaminated by bacteria, foreign objects or undisclosed allergens.
Advertisement
Cleveland Clinic is a non-profit academic medical center. Advertising on our site helps support our mission. We do not endorse non-Cleveland Clinic products or services. Policy
A recall may follow an outbreak of food-borne illness, caused by food-borne pathogens such as salmonella or listeria. It may also follow detection of a contaminant in a plant or facility where food is processed, before it reaches humans or when it is mislabeled.
Recall notices are usually specific, detailing the months in which the product was sold, the locations, the expiration dates and even parts of serial numbers.
You usually know you’ve eaten a contaminated product by the symptoms that emerge after consumption. Some are mild, but allergic reactions to undisclosed dairy, nuts, eggs, gluten or soy can be quite serious. So can reactions to sulfites in those with sensitivity.
Symptoms reported with food recalls include:
If you are pregnant, have a compromised immune system or are very young or very old, contact your doctor’s office if you think you’ve eaten contaminated food. If you believe you’re having an allergic reaction to a food, follow your doctor’s instructions for promptly managing your reaction.
Knowledge is power. To limit future exposure to contaminated foods, sign up for FDA food safety recall alerts at www.fda.gov/Safety/Recalls/ or www.foodsafety.gov/recalls/.
Advertisement
—Registered dietitian Nicole Hopsecger, RD, LD.
Advertisement

Sign up for our Health Essentials emails for expert guidance on nutrition, fitness, sleep, skin care and more.
Learn more about our editorial process.
Advertisement
Leftovers can be kept in the fridge for three to four days or frozen for three to four months
Ultimately, rice is safe to eat, but the type, where it’s grown and how you cook it may be factors to consider
Washing your hands, thoroughly cleaning kitchen tools and preparing meat separately can reduce the risk of foodborne illness
Rinsing raw chicken raises the risk of spreading harmful bacteria and causing foodborne illness
Extended outages lasting more than four hours can make food in your fridge unsafe to eat
Make your home a no-fly zone by cleaning your drains, refrigerating your produce and DIYing a fruit fly trap
Microwaves use non-ionizing radiation and haven’t been shown to cause cancer — follow food safety practices and use microwave-safe containers
Once perishable food hits the table, it’s typically good for about two hours
Fill your plate with lean proteins, non-starchy vegetables and complex carbohydrates
With time and patience and trial and error, you may be able to find relief from keratosis pilaris (KP) symptoms
Thumb sucking is a normal part of early development, but over time, it can affect teeth, speech and habits